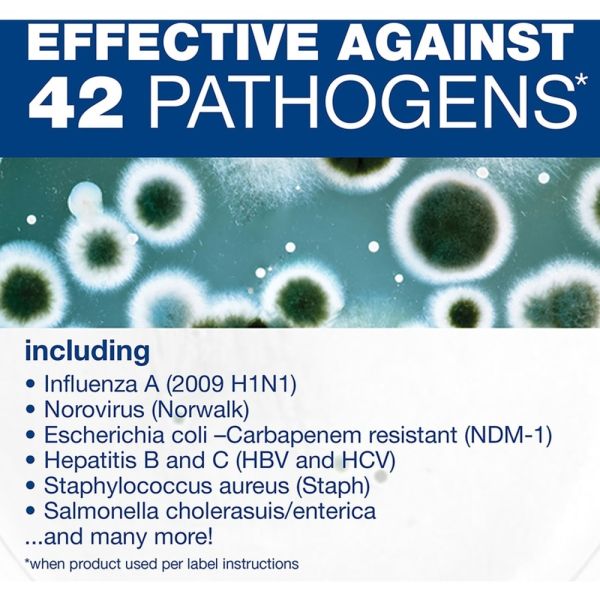
Image 10

Loading...
Comet Professional Multi Purpose Disinfecting Liquid Cleaner with Bleach Spray, 32 fl oz
Product #:
ODFN6188845





 +12
+12View All
Sold Out
This product is sold out and we do not know when we will be getting another shipment. We apologize for any inconvenience this may cause.
Check similar items above to see if a replacement product is available.
Product Description
Comet Professional Multi Purpose Disinfecting Liquid Cleaner with Bleach Spray, 32 fl oz
Clean and deodorize your space with Comet Professional Disinfecting Cleaner With Bleach. This powerful 2-in-1 cleanser combines heavy-duty detergents with bleach to cut through soap scum and kill pathogens while it leaves behind a pleasant scent.
- Ideal for use on toilets, sinks, chrome, tile, tubs and fiberglass.
- Designed to cut through soap scum to leave surfaces clean and sanitized.
- 2-in-1 formula combines heavy-duty detergents with bleach.
- Deodorizes as it cleans.
- Contains no abrasives.
- Kills pathogens including Hepatitis B and Influenza A.
Product Specifications
-
Brand NameComet
-
Container TypeSpray Bottle
-
Country of OriginUS
-
FeaturesPhenol Free
-
FragranceFresh
-
ManufacturerTHE PROCTER & GAMBLE COMPANY
-
Manufacturer Part Number75350
-
Product FormLiquid
-
Product LineProfessional Disinfecting Cleaner With Bleach
-
Product TypeDisinfectant Cleaner
-
RefurbishedN
-
TypeDisinfectant